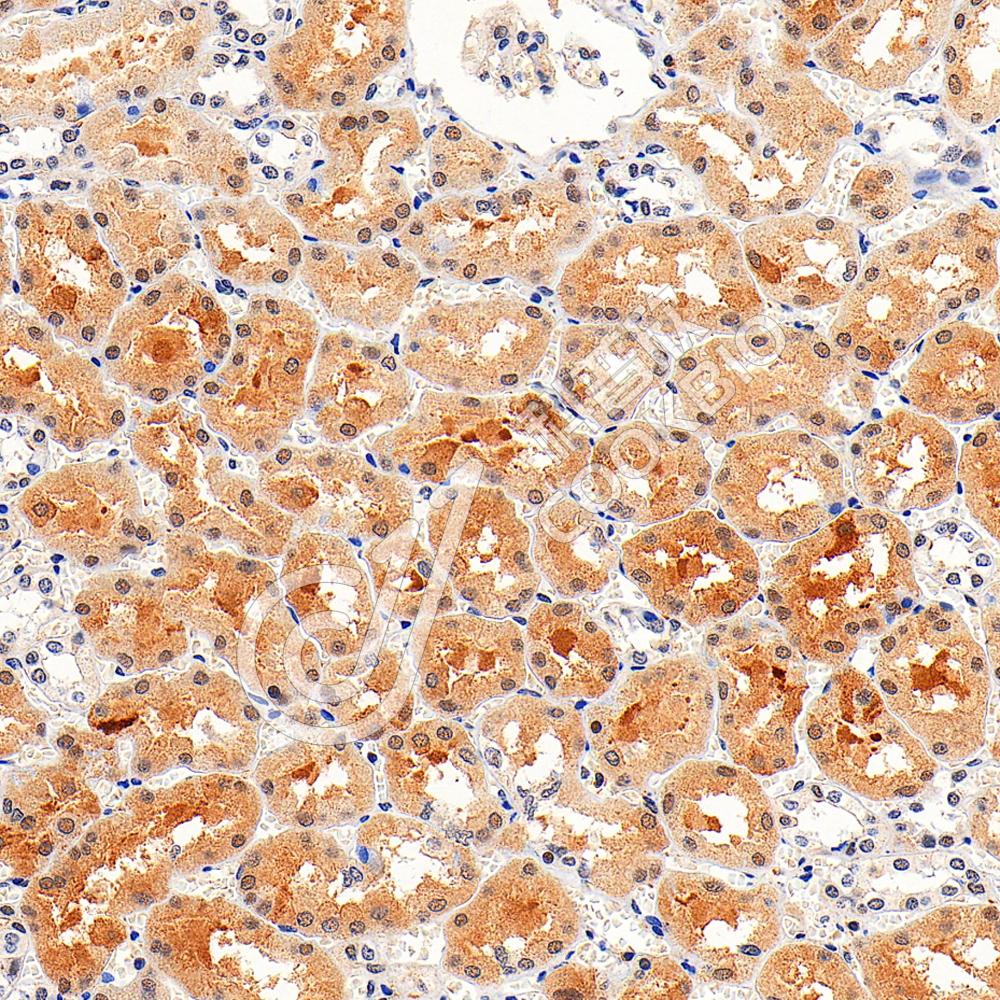

产品信息
| 蛋白质全称 | 细胞分裂周期和细胞凋亡调节蛋白 1 |
|---|---|
| 别名 | CARP-1,CARP1,FLJ10590 |
| Uniprot ID | Q8CH18 |
| 免疫原 | 小鼠DIS重组蛋白 |
| 抗体亚型 | IgG |
| 纯化方式 | 亲和纯化 |
| 亚细胞定位 | 细胞质 |
| 预测分子量./观测分子量. | 132 kDa / 128 kDa |
应用
WB 免疫印迹
物种:小鼠,大鼠
稀释比:1:2000-1:4000
阳性样品:肾
IHC/IF 免疫组织化学/免疫荧光
物种:人,小鼠,大鼠
稀释比:1:2000-1:6000
阳性样品:肾, 睾丸
背景
Associates with components of the Mediator and p160 coactivator complexes that play a role as intermediaries transducing regulatory signals from upstream transcriptional activator proteins to basal transcription machinery at the core promoter. Recruited to endogenous nuclear receptor target genes in response to the appropriate hormone. Also functions as a p53 coactivator. May thus play an important role in transcriptional regulation. May be involved in apoptosis signaling in the presence of the retinoid CD437. Apoptosis induction involves sequestration of 14-3-3 protein(s) and mediated altered expression of multiple cell cycle regulatory genes including MYC, CCNB1 and CDKN1A. Plays a role in cell cycle progression and/or cell proliferation.
储存条件
储存条件:储存条件在:-20℃下储存一年, 避免反复冻融.
储存缓冲液:含0.15% ProClin300防腐剂, 100 μg/mL牛血清白蛋白和50%甘油的磷酸盐缓冲液.
图像

WB检测DIS蛋白(货号 K1342747).
样品: 经RIPA裂解液(货号KSG2002)处理的蛋白质.
封闭: 3%脱脂牛奶(货号KSGC310001)溶于TBST溶液, 室温孵育1小时.
—抗: 1: 2000稀释, 4℃ 孵育过夜.
二抗: HRP标记山羊抗兔IgG (H+L) (货号KB69909), 1: 5000稀释, 室温孵育1小时.
样品: 经RIPA裂解液(货号KSG2002)处理的蛋白质.
封闭: 3%脱脂牛奶(货号KSGC310001)溶于TBST溶液, 室温孵育1小时.
—抗: 1: 2000稀释, 4℃ 孵育过夜.
二抗: HRP标记山羊抗兔IgG (H+L) (货号KB69909), 1: 5000稀释, 室温孵育1小时.
IHC检测DIS蛋白(货号 K1342747).
样品: 人肾, 4%多聚甲醛 (货号KSG1101) 固定12-24小时.
抗原修复: Tris-EDTA抗原修复液(pH 9.0) (KSG1203), 98℃, 20分钟.
—抗: 1: 4000稀释, 4℃ 孵育过夜.
二抗: S-vision免疫组化多聚二抗(山羊抗兔),即用型 (货号KB3906), 室温孵育20分钟.
样品: 人肾, 4%多聚甲醛 (货号KSG1101) 固定12-24小时.
抗原修复: Tris-EDTA抗原修复液(pH 9.0) (KSG1203), 98℃, 20分钟.
—抗: 1: 4000稀释, 4℃ 孵育过夜.
二抗: S-vision免疫组化多聚二抗(山羊抗兔),即用型 (货号KB3906), 室温孵育20分钟.

IHC检测DIS蛋白(货号 K1342747).
样品: 小鼠睾丸, 4%多聚甲醛 (货号KSG1101) 固定12-24小时.
抗原修复: Tris-EDTA抗原修复液(pH 9.0) (KSG1203), 98℃, 20分钟.
—抗: 1: 4000稀释, 4℃ 孵育过夜.
二抗: S-vision免疫组化多聚二抗(山羊抗兔),即用型 (货号KB3906), 室温孵育20分钟.
样品: 小鼠睾丸, 4%多聚甲醛 (货号KSG1101) 固定12-24小时.
抗原修复: Tris-EDTA抗原修复液(pH 9.0) (KSG1203), 98℃, 20分钟.
—抗: 1: 4000稀释, 4℃ 孵育过夜.
二抗: S-vision免疫组化多聚二抗(山羊抗兔),即用型 (货号KB3906), 室温孵育20分钟.

IHC检测DIS蛋白(货号 K1342747).
样品: 大鼠睾丸, 4%多聚甲醛 (货号KSG1101) 固定12-24小时.
抗原修复: Tris-EDTA抗原修复液(pH 9.0) (KSG1203), 98℃, 20分钟.
—抗: 1: 4000稀释, 4℃ 孵育过夜.
二抗: S-vision免疫组化多聚二抗(山羊抗兔),即用型 (货号KB3906), 室温孵育20分钟.
样品: 大鼠睾丸, 4%多聚甲醛 (货号KSG1101) 固定12-24小时.
抗原修复: Tris-EDTA抗原修复液(pH 9.0) (KSG1203), 98℃, 20分钟.
—抗: 1: 4000稀释, 4℃ 孵育过夜.
二抗: S-vision免疫组化多聚二抗(山羊抗兔),即用型 (货号KB3906), 室温孵育20分钟.
需要技术支持?
如果您有任何问题或如果您在实验过程中遇到问题,或需要更详细的技术指导,请联系我们的技术支持团队
 400-6027-270
400-6027-270
联系我们
如果您对我们的公司或产品有任何疑问,欢迎随时联系我们





















 湖北省武汉市东湖新技术开发区高新二路388号生物医药加速器22栋5楼
湖北省武汉市东湖新技术开发区高新二路388号生物医药加速器22栋5楼  400-6027-270
400-6027-270  鄂公网安备42018502008544号
鄂公网安备42018502008544号